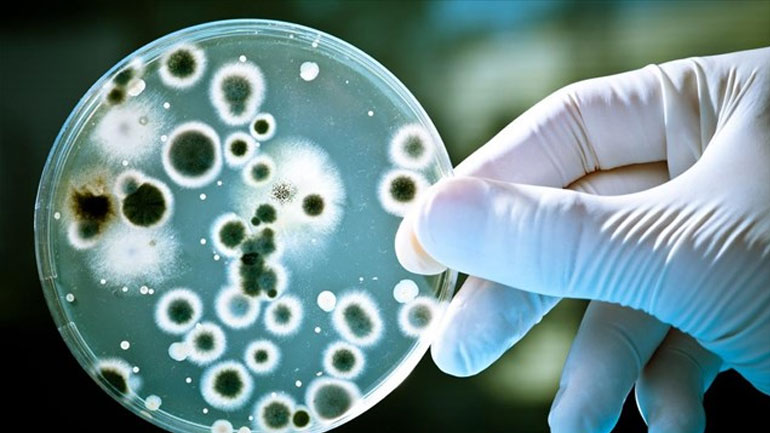
Συναγερμός στην Ευρώπη για επικίνδυνο βακτήριο Συναγερμός στην Ευρώπη για επικίνδυνο βακτήριο

Ένα βακτήριο που αποτελεί επιβλαβή οργανισμό καραντίνας για τα ελαιόδεντρα και είναι δυνητικά επικίνδυνο για μεγάλη ποικιλία άλλων σημαντικών φυτών για την γεωργία της ΕΕ, όπως η άμπελος και τα εσπεριδοειδή, σήμανε συναγερμό στα κράτη μέλη της ΕΕ.
Εμπειρογνώμονες, στο πλαίσιο της Μόνιμης Επιτροπής φυτών, ζώων, τροφίμων και ζωοτροφών (PAFF) ενέκριναν χθες τη λήψη ενισχυμένων μέτρων, με βάση πρόταση της Επιτροπής, για την πρόληψη της περαιτέρω εισαγωγής και εξάπλωσης εντός της ΕΕ του βακτηρίου Xylella fastidiosa. Με τα νέα μέτρα της ΕΕ τα κράτη μέλη υποχρεούνται να κοινοποιούν την εκδήλωση νέων κρουσμάτων στην ΕΕ, να διενεργούν επίσημες έρευνες και να οριοθετηθούν άμεσα τις προσβεβλημένες περιοχές.
Στις περιοχές αυτές εφαρμόζονται αυστηρά μέτρα εξάλειψης, τα οποία περιλαμβάνουν την απομάκρυνση και καταστροφή των προσβεβλημένων φυτών και όλων των φυτών ξενιστών σε ακτίνα 100 μέτρων, ανεξάρτητα από την κατάσταση της υγείας τους. Ειδικά για την Ιταλία, τα μέτρα προβλέπουν τη δυνατότητα να εφαρμόσει μέτρα περιορισμού σε ολόκληρη την επαρχία του Lecce, όταν δεν είναι πλέον δυνατή η εξάλειψη. Στην περίπτωση αυτή, θα εφαρμοστεί το μέτρο συστηματικής απομάκρυνσης όλων των προσβεβλημένων φυτών και η ανάλυση των γειτονικών φυτών (σε απόσταση 100 μέτρων) σε ζώνη 20 χιλιομέτρων που γειτονεύει με τις επαρχίες του Μπρίντεζι και του Τάραντα.
Η εισαγωγή και κυκλοφορία εντός της Ένωσης συγκεκριμένων φυτών που είναι γνωστό ότι μπορούν να προσβληθούν από το βακτήριο Xylella fastidiosa παγκοσμίως, θα υπόκειται σε αυστηρούς περιορισμούς. Ειδική απαγόρευση έχει θεσπιστεί σχετικά με την εισαγωγή φυτών καφέ από την Ονδούρα και την Κόστα Ρίκα, λαμβανομένου υπόψη του υψηλού κινδύνου προσβολής από το βακτήριο.
Η παρουσία του Xylella fastidiosa στην ΕΕ κοινοποιήθηκε για πρώτη φορά από τις ιταλικές αρχές στις 21 Οκτωβρίου 2013. Η περιοχή που επλήγη από τον οργανισμό αυτό είναι το σύνολο της επαρχίας του Lecce στη νότια Ιταλία, με την εκδήλωση νέας εστίας που επιβεβαιώθηκε πρόσφατα στη γειτονική επαρχία του Μπρίντεζι. Μέτρα έκτακτης ανάγκης σε επίπεδο ΕΕ ελήφθησαν για πρώτη φορά το Φεβρουάριο του 2014 και εξειδικεύτηκαν περαιτέρω τον Ιούλιο του 2014.
Η έλλειψη αποτελεσματικών θεραπειών για τα φυτά από τη στιγμή που έχουν προσβληθεί, το ευρύ φάσμα των φυτικών ειδών που είναι γνωστό ότι είναι ευάλωτα στο βακτήριο, καθώς και η αυξημένη πιθανότητα περαιτέρω εξάπλωσης και εγκατάστασης στην ΕΕ, καθιστούν το εν λόγω βακτήριο μια πολύ σοβαρή απειλή για το γεωργικό τομέα της ΕΕ.